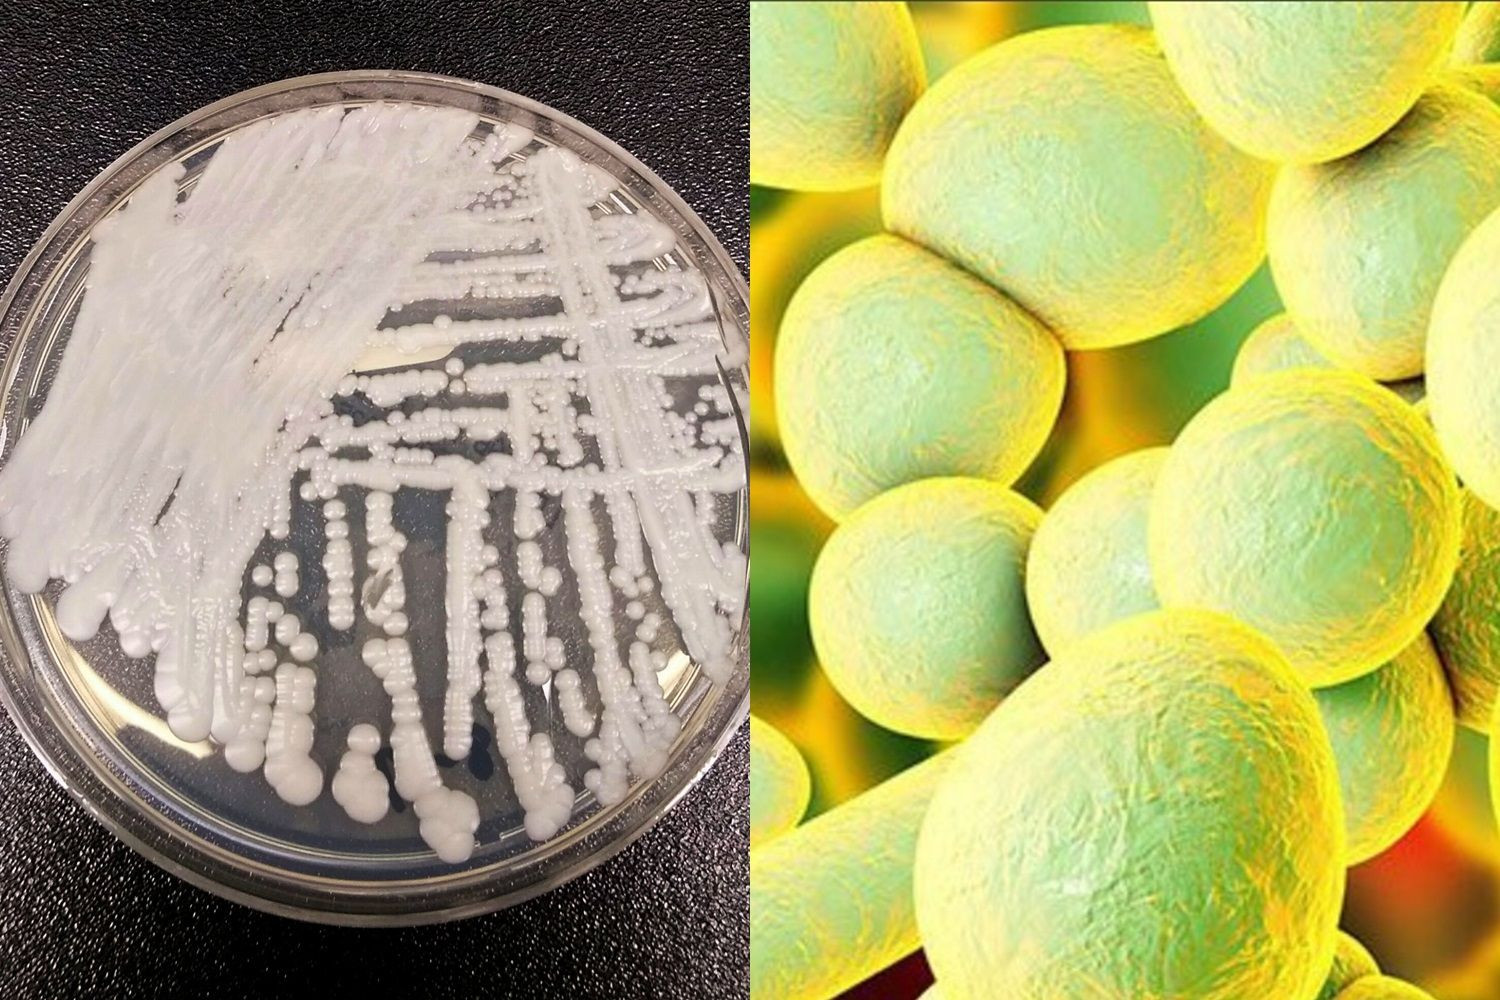

โลกร้อนทำแบคทีเรียดื้อยาระบาด มนุษย์เสี่ยงเข้าสู่ยุคไร้ยาฆ่าเชื้อโรค
วิจัยชี้ภาวะโลกร้อนเป็นตัวการสำคัญทำให้เชื้อโรคดื้อยาปรับตัวและแพร่กระจายไปทั่วโลก
วิจัยชี้ภาวะโลกร้อนเป็นตัวการสำคัญทำให้เชื้อโรคดื้อยาปรับตัวและแพร่กระจายไปทั่วโลก
เมื่อ 10 ปีที่แล้ว เชื้อยีสต์สายพันธุ์ Candida auris ที่ดื้อยาปฏิชีวนะกลายเป็นภัยคุกคามร้ายแรงทางสาธารณสุขโลก เพราะในบางเคสเชื้อดื้อยาชนิดนี้เป็นต้นเหตุของการติดเชื้อในกระแสเลือดจนผู้ป่วยเสียชีวิต โดยพบเชื้อดังกล่าวครั้งแรกในหูของคนไข้ชาวญี่ปุ่นรายหนึ่งที่มีอาการอักเสบ จากนั้นก็พบการแพร่ระบาดในเกาหลีใต้ สหรัฐ ทวีปเอเชียและยุโรป และกลับมาระบาดในอินเดีย เวเนซุเอลา และแอฟริกาใต้ระหวางปี 2012-2015 ทว่านักวิทยาศาสตร์ก็ยังไม่สามารถหาสาเหตุที่เชื้อดื้อยานี้ระบาดขึ้นพร้อมๆ กันใน 3 ประเทศที่อยู่คนละทวีปได้ เนื่องจากเชื้อดังกล่าวตรวจพบได้ยาก ต้องอาศัยเครื่องมือและวิธีการเฉพาะในห้องแล็บเท่านั้น
แต่ล่าสุดทีมนักวิทยาศาสตร์จากสหรัฐและเนเธอร์แลนด์พบทฤษฎีใหม่ว่าด้วยการแพร่ระบาดของเชื้อ Candida auris ซึ่งตีพิมพ์ลงในวารสาร mBio ของสมาคมชีววิทยาของสหรัฐ ว่าภาวะโลกร้อนอาจเป็นกุญแจสำคัญที่ทำให้เชื้อที่ว่าแพร่ระบาดคุกคามชีวิตมนุษย์ไปทั่วโลก
โดยปกติแล้วการติดเชื้อราในมนุษย์เกิดขึ้นไม่บ่อยนัก เนื่องจากเชื้อราส่วนใหญ่ไม่สามารถเติบโตในอุณหภูมิร่างกายมนุษย์ และมนุษย์เรายังมีภูมิคุ้มกันเป็นตัวปกป้องอีกชั้นหนึ่ง ทว่าจากการศึกษาเปรียบเทียบระหว่างเชื้อ Candida auris และเชื้อที่สปีชีส์ใกล้เคียงกันมากที่สุดพบว่า เชื้อ Candida auris สามารถปรับตัวและเติบโตได้ในอุณหภูมิที่สูงขึ้นตามไปด้วย นั่นก็หมายความว่ามันทนต่ออุณหภูมิร่างกายมนุษย์ได้สบายๆ
อย่างไรก็ดี ผู้เชี่ยวชาญชี้ว่าแม้จะเป็นปัจจัยหลักแต่ภาวะโลกร้อนไม่ใช่สาเหตุเดียวที่ทำให้เชื้อยีสต์ตัวร้ายนี้อุบัติขึ้นมา การใช้ยาปฏิชีวนะแบบผิดวิธีหรือใช้มากเกินไป ตลอดจนการใช้ยาฆ่าเชื้อราอย่างแพร่หลายในการทำการเกษตร ล้วนมีส่วนทำให้เชื้อเหล่านี้ดื้อยา และยังเตือนว่าแม้นักวิทยาศาสตร์จะระบุเป็นครั้งแรกว่าการอุบัติของเชื้อ Candida auris มีส่วนเกี่ยวข้องกับภาวะโลกร้อน แต่คาดว่าจะยังมีเชื้ออื่นๆ วิวัฒนาการตัวเองให้ทนต่อความร้อนตามมาอีก
สอดคล้องกับ เตจัส บูร์คลาส ผู้ช่วยศาสตราจารย์คณะวิทยาศาสตร์ชีววิทยาของมหาวิทยาลัยลองไอส์แลนด์ ที่เผยว่า เชื้อ Candida auris สามารถช่วยให้เชื้อราชนิดอื่นพัฒนาตัวเองจนกลายเป็นภัยร้ายคุกคามมนุษย์ได้ผ่านการถ่ายทอดดีเอ็นเอไปยังเชื้อราในสปีชีส์ Candida ตัวอื่นโดยการผสมพันธุ์ ซึ่งหากวันนั้นมาถึงมนุษย์คงต้องเผชิญกับโรคที่ไม่รู้จักอีกนับไม่ถ้วน
นอกจากนี้ ยังมีเรื่องที่น่ากังวลไม่แพ้กันคือ ในขณะที่เชื้อโรคกำลังวิวัฒนาการตัวเองให้ทนต่อยาปฏิชีวนะที่มีอยู่บนโลกใบนี้ การวิจัยเพื่อพัฒนายาปฏิชีวนะตัวใหม่กลับไม่คืบหน้า ยาปฏิชีวนะที่จำหน่ายในท้องตลาดตลอดช่วง 30 ปีที่ผ่านมาล้วนพัฒนาต่อยอดมาจากยาปฏิชีวนะที่ค้นพบตั้งแต่ปี 1984 หรือเมื่อ 35 ปีที่แล้ว และที่ยิ่งน่าเป็นห่วงคือ การค้นพบยาปฏิชีวนะตัวใหม่ที่ใช้รักษาเชื้อดื้อยาแกรมลบบนโลกนี้ต้องย้อนกลับไปถึง 57 ปีที่แล้ว
สาเหตุเป็นเพราะการคิดค้นยาปฏิชีวนะค่อนข้างซับซ้อนและยาตัวใหม่ๆ ก็ไม่สามารถวางจำหน่ายได้อย่างเสรี เพราะต้องเก็บยาจำนวนหนึ่งไว้สำหรับกรณีฉุกเฉิน ทำให้บริษัทยาขาดแรงดึงดูดในการลงทุน ประกอบกับในช่วง 30 ปีที่ผ่านมาบริษัทยาทั่วโลกส่วนใหญ่ปรับลดการพัฒนายาปฏิชีวนะ แล้วหันไปพัฒนายารักษาโรคเรื้อรังที่สร้างรายได้ได้มากกว่าแทน
หากสถานการณ์ยังเป็นเช่นนี้ต่อไป จิม โอนีลล์ นักเศรษฐศาสตร์ชื่อดังวิเคราะห์ว่าภายในปี 2050 เชื้อดื้อยาจะคร่าชีวิตพลเมืองโลกราว 10 ล้านคนต่อปี หรือมากกว่าจำนวนผู้เสียชีวิตจากโรคมะเร็งในปัจจุบัน ซึ่งจะส่งผลเสียหายต่อเศรษฐกิจราว 100 ล้านล้านเหรียญสหรัฐ หรือ 3,089 ล้านล้านบาท







